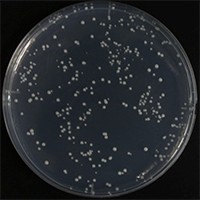
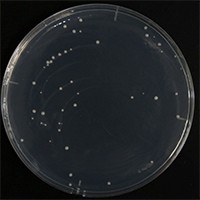

ELEPO21
ELEPO21 In Vitro High Energy Electroporator
Bacterial Cells, Mammalian Cells and More

ELEPO21 In Vitro Applications
- Hi Voltage Electroporation
- Transformation of
- - Bacterial Cells
- - Fungi, Yeasts, etc.
- Up to 3,000 Volt pulses at millisecond (not microsecond) range can be delivered.
- Remarkably higher transformation efficiency than traditional electroporation
- Low Voltage Electroporation
- Transfection of
- - Primary Cell Cultures
- - Any Cell Lines (animal cells and plant cells)
- - Stem Cells, ES Cells, iPS Cells, etc.
- High transfection efficiency and high viability without special buffer
*The ELEPO21 electroporator can cover all
application range of the second-class CUY21 electroporators.
*This
instrument complies with CE marking, UL standard and CSA
standard.
| Request a Demo |
| See the performance of the ELEPO21 electroporator with your cells. |
ELEPO21 Novel 4-Step Multiple Electroporation Pulse

The novel 4-step pulse with natual voltage decay results in higher transformation/transfection efficiency and higher viability.
1) Poring Pulse Mode:
higher voltage, shorter duration, multiple pulses, natural voltage decay
This poring pulse is for forming pores
(small holes) in cell membrane with minimum damage.
2) Polarity Exchanged Poring Pulse
The polarity of Poring pulse can be reveresed.
3) Transfer Pulse Mode:
lower voltage, longer duration, multiple pulses, natural voltage dcay.
This transfer pulse is for
delivering the target molecules (DNA, RNA, etc.) into cells with minimum
damage.
4) Polarity Exchanged Transfer Pulse
This can increase the transfection efficiency.
Hi Voltage Electroporation
The ELEPO21 In Vitro High-Voltage Electroporator developed by Nepa Gene Co., Ltd. has a unique pulsing system composed of 4-step multiple pulses with decaying, and it can achieve transformation efficiency markedly higher than traditional methods that use a single-step exponential pulse wave in bacteria, yeasts, and fungi.
High-effciency gene transfer in bacteria by multi-step electroporation
- Transformation data of bacteria (E. coli) -
We measured gene transfer efficiency using the ELEPO21 in Gram-negative bacteria. Competent cells were prepared as usual from E. coli DH5α. The competent cells were mixed with pUC19 DNA, and a 20μl aliquot (containing 10^9-10^11 cells and 10 pg DNA in 10% glycerol solution) was transferred to the 1 mm gap electrode cuvette (EC-001S, Nepa Gene). The cuvette was set in the chamber connected to the ELEPO21, and delivered 3-step pulses as described below. All steps were done on ice. After electroporation, the cells were plated on LB agarose medium containing ampicillin, and colonies formed were counted. Transformation efficiency was expressed as a number of colonies per ug plasmid DNA used.
[ELEPO21 pulsing conditions, Fig. 1]
Poring Pulse (voltage: 2,000 V, pulse length: 2.5 msec, pulse interval: 50 ms, number of pulse: 1, polarity: +)
Transfer Pulse (voltage: 150 V, pulse length: 50 msec, pulse interval: 50 ms, number of pulse: 5, polarity: +/-)
To evaluate the above results, we measured gene transfer efficiencies using a conventional electroporator (ECM630, BTX) that deliver a single exponential pulse as described below.
[ECM630 pulsing conditions, Fig. 2]
Single pulse (voltage: 2,000 V, resistance: 200 ohms, capacitance: 25 uF, number of pulse: 1)
| Fig. 1: ELEPO21 pulse shape | Fig. 2: ECM630 pulse shape |
![]() |
![]() |
| Fig. 3 |
![]() |
Experimental results:
The above cell suspensions (sample resistance value: 7.7 K ohms) were used for electroporation. The tranformation efficiency obtained by the ELEPO21 electroporator was approximately 5 times higher than that by the ECM630 electroporator (Fig. 3).
*The values are averages of repeated experiments.
*The optimum pulsing conditions were used for ELEPO21 and ECM630.
*cfu: colony forming unit.
High-effciency gene transfer in Yeast by multi-step electroporation
- Transformation data of Yeast (S. cerevisiae) -
We measured gene transfer efficiency using the ELEPO21 in yeast. Competent cells were prepared as usual from budding yeast S. cerevisiae. The competent cells were mixed with pAS2 DNA, and a 20μl aliquot (containing 108-1010 cells and 50 ng DNA in 1M sorbitol solution) was transferred to the 1 mm gap electrode cuvette (EC-001, Nepa Gene). The cuvette was set in the chamber connected to the ELEPO21, and delivered 3-step pulses as described below. All steps were done on ice. After electroporation, the cells were plated on selective agarose medium devoid of nutrients, and the colonies formed were counted. Transformation efficiency was expessed as a number of colonieis per μg plasmid DNA.
[ELEPO21 pulsing conditions, Fig. 1]
Poring Pulse(voltage: 2,000 V, pulse length:2.5 msec, pulse interval:50 ms, number of pulse:1, polarity:+)
Transfer Pulse(voltage: 150 V, pulse length:50 msec, pulse interval:50 ms, number of pulse:5, polarity:+/-)
To evaluate the above results, we measured gene transfer efficiencies using a conventional electroporator (ECM630, BTX) that deliver a single exponential pulse as described below.
[ECM630 pulsing conditions, Fig. 2]
Single pulse (voltage:2,000 V, resistance:200Ω, capacitance:25μF, number of pulse:1)
| Fig. 1: ELEPO21 | Fig. 2: ECM630 |
![]() |
![]() |
| Fig. 3 |
![]() |
Experimental results:
The above cell suspensions (sample resistance value:12.36 KΩ) were used for electroporation. The tranformation efficiency obtained by the ELEPO21 was approximately 6 times higher than that by the ECM630 electroporator (Fig. 1-3).
*The values are averages of repeated experiments.
*The optimum pulsing conditions were used for ELEPO21 and ECM630.
*cfu: colony forming unit.
Low Voltage Electroporation
It is possible to achieve high transfection efficiency and high viability without resourse to special buffers for difficult-to-transfect cells such as primary cells, stem cells, immune cells, blood cells, etc.
Transfection into Primary Cells
| BMMC Primary Mouse Bone Marrow-Derived Mast cells | |
![]() |
![]() |
| Viability: 61% | Transfection Efficiency: 68% |
| FACS Data |
![]() |
See MORE.
*The transfection data above are from the NEPA21 but we confirm that the ELEPO21 can achieve consistent results similar to the NEPA21.
Transfection into Stem Cells: ESCs, iPSCs and more
| Human iPS Cells | Human ES Cells |
![]() |
![]() |
| 3 days after electroporation | Stable expression |
| Mouse Neurospheres | |
![]() |
![]() |
| Viability: 90% | Transfection Efficiency: 75% |
See MORE.
*The transfection data above are from the NEPA21 but we confirm that the ELEPO21 can achieve consistent results similar to the NEPA21.
Transfection into Cell Lines
| 293T (HEK293T): Human Embryonic Kidney Cells | |
![]() |
![]() |
| Viability: 83% | Transfection Efficiency: 87% |
| Jurkat: Human T-cell Leukemia Cells | |
![]() |
![]() |
| Viability: 90% | Transfection Efficiency: 85% |
See MORE.
*The transfection data above are from the NEPA21 but we confirm that the ELEPO21 can achieve consistent results similar to the NEPA21.
Comparison with Competitors
No Special Buffers for the ELEPO21!!
| Transfection Device |
ELEPO21 (Nepa Gene) |
Competitor N (Company L) |
Competitor N (Company I (L)) |
| Characteristics | New Electroporation No Special Buffers |
Electroporation and Special Buffers |
Electroporation and Special Tips |
| Transfection Efficiency |
|||
| Cell Viability | |||
| Consumables (Disposable Kits) |
Economy Cuvettes USD 2.00/reaction |
Special Kits USD 20.00/reaction |
Special Kits USD 20.00/reaction |
Is your lab still using a transfection device that requires expensive disposable kits?
We hear from a lot of researchers that they are not satisfied with its high running cost.
The running cost of ELEPO21 is much lower than other transfection devices!
| Super Electroporator ELEPO21 | |||
| Dimensions | 432(W) X 336(D) X 116(H) mm | Weight | 8.7 kg |
*All features and specifications subject to change without notice.